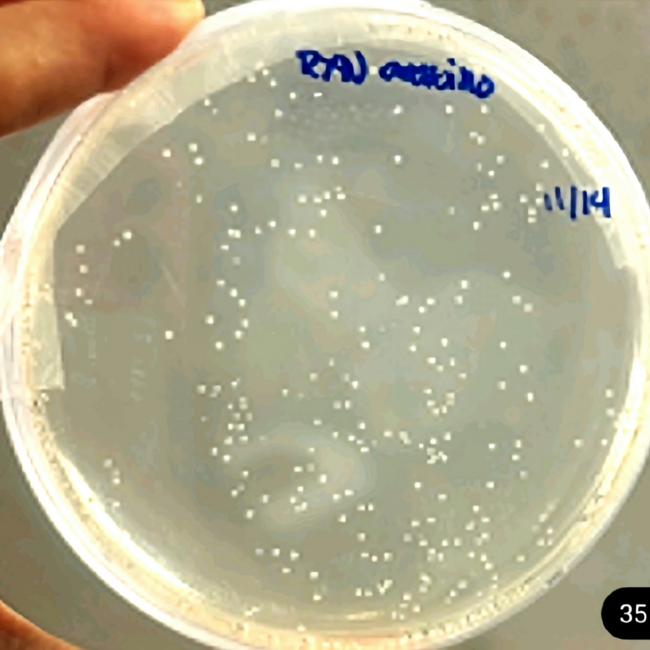

Microbacterium arabinogalactanolyticum
(마이크로박테리움 아라비노갈락타놀리티쿰)
환경부 산하 국립낙동강생물자원관(관장 용석원)은 최근 유전자변형 없이 과당*을 저당 감미료인 알룰로스로 전환할 수 있는 미생물 균주 발굴에 성공했다고 밝혔다.
* 과당: 단당류의 일종으로, 과일이나 옥수수 시럽 등에 많이 함유되어 있으며, 설탕보다 단맛이 강함. 과당의 과도한 섭취는 건강에 부정적인 영향을 미칠 수 있음
알룰로스는 설탕과 유사한 단맛을 지니면서도 칼로리가 거의 없고 혈당을 올리지 않는 저당 감미료로, 항산화 및 항비만 효과도 있는 것으로 보고되고 있다. 최근 세계 대체당 시장이 연평균 5.7% 이상 급성장하면서 알룰로스는 식품업계의 주요 전략 소재로 주목받고 있다.
대부분의 미생물은 자연 상태에서는 알룰로스를 효율적으로 생산하지 못하기 때문에, 현재 식품 산업에서는 알룰로스 생산 능력을 향상시킨 유전자변형(GMO) 균주를 활용한 생산 기술이 많이 사용되고 있다. 그러나 '유전자변형(GMO) 완전표시제' 도입 논의가 본격화되면서 국내 식품업계의 비유전자변형(Non-GMO) 균주 수요가 크게 증가하고 있다.
이번 연구에서 국립낙동강생물자원관은 보유하고 있는 미생물 자원을 활용해 알룰로스 생산 능력을 가진 균주 5종을 선별하고, 이들로부터 유래한 알룰로스 합성 효소의 정제 및 기능 분석을 진행했다.
해당 연구결과를 바탕으로 마이크로박테리움 아라비노갈락타놀리티쿰(Microbacterium arabinogalactanolyticum) 종의 미생물에 대한 특허가 8월 중에 출원되고, 추가로 마이크로박테리움 파라옥시단스(M. paraoxydans) 종의 미생물에 대한 특허 또한 9월 초에 추가로 출원될 예정이다.
연구진은 이들 균주에서 유래한 효소가 기존에 알려진 효소에 비해 섭씨 70도 이상의 고온에서도 활성률이 높고, 알룰로스 전환율 또한 우수함을 확인했다.
이번 연구는 유전자변형 없는 천연 미생물을 활용해 소비자 신뢰도가 높은 알룰로스 생산 기술 개발의 기반을 마련한 것으로, 향후 식품 및 바이오 산업에서 국내 대체당 소재의 세계 시장 경쟁력 강화에 기여할 것으로 기대된다.
김의진 국립낙동강생물자원관 생물자원연구실장은 “소비자 우려를 최소화하면서도 고기능성 감미료를 생산할 수 있다는 점에서 관련 산업에 미치는 파급력이 클 것”이라며, “향후 생산 공정 최적화 등 관련 연구를 통해 미생물 기반 대체당 원료의 자체 기술 확보 및 산업화에 더욱 노력할 계획”이라고 밝혔다.
자료출처 : 환경부 누리집
전남 신안군, 짱뚱어다리
솔무등공원과 우전해변 사이 갯벌위에 세워진 470m의 짱뚱어다리는 증도 여행의 필수 코스로서 다리 아래로 무수히 많은 갯벌생물이 관찰됨. 우전해변은 비치파라솔이 설치되어 이국적인 풍경으로 최근 영화 ‘덕혜옹주’ 촬영지였음. 자료출처 : 전라남도 누리집
여수 금오도
문화체육관광부의 ‘2026 씨-너지 섬-기업 상생 관광 프로젝트’ 공모사업에 선정된 여수 금오도,자료출처 : 전라남도 대표누리집
벋음양지꽃
전세계에서 한반도 중부(강원, 경기, 경북, 충북 등) 지역에만 분포하는 여러해살이풀(고유종)로노란색 꽃이 4월에서 6월에 피며, 뿌리의 형태를 따서 이름이 지어졌다. ,자료출처 : 기후에너지환경부>
김혜경 여사, 설맞이 한복인 신년회
김혜경 여사는 6일, 2026 설맞이 한복인 신년회에 참석했다.
안동 월영교
국내에서 가장 긴 목책 인도교출처 : 경상북도 누리집